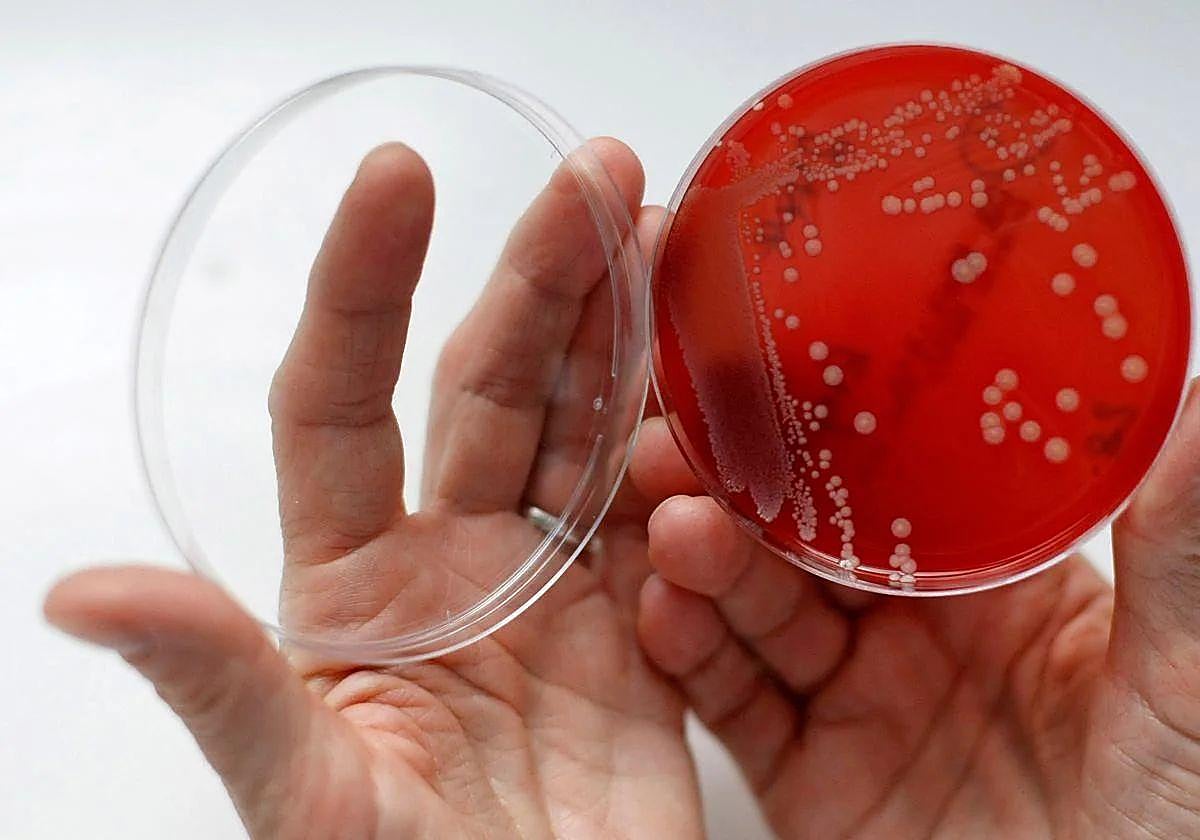
Las superbacterias causan 24.000 muertes al año en España.

Una investigación alerta del descenso del PIB por efecto de las superbacterias
La resistencia antimicrobiana nos supondrá dos billones de dólares en 2050, no solo por sus costes sanitarios, sino por los laborales
Las superbacterias, esas que no responden a los antibióticos conocidos, no son solo un problema de salud, también de dinero. Siempre que se dan cifras, ... se habla del número de infecciones que generan y también de las muertes que se derivan de ellas. Pero un nuevo estudio plantea su importancia para la economía mundial y cifra en dos billones de dólares lo que podría costarnos sus efectos en 2050.
El informe, realizado por el Center for Global Developement y financiado por el gobierno británico, pone sobre la mesa la necesidad de seguir invirtiendo en este capítulo haciendo énfasis donde más duele: la cartera. Además de esos dos billones de dólares del PIB mundial, los investigadores detallan otras cifras, como el coste de los tratamientos para estos casos y la pérdida de fuerza laboral que producen.
En el primer caso, la carga económica por estas bacterias multirresistentes es muy importante. No solo por el precio de los tratamientos, que son más complejos, sino porque aumenta el número de pacientes en los hospitales, y alarga las estancias de los enfermos en estos centros. Ahora mismo este capítulo exige una inversión de 66.000 millones de dólares al año, que se convertirían en 159.000 para 2050 en el escenario más pesimista.
En el segundo caso, el mercado laboral vería aumentar el número de bajas por enfermedad y reducirse el grueso de mano de obra por las muertes. Solo en España, cada año fallecen 24.000 personas a causa de las superbacterias, ocho veces más de lo que estimaban los servicios públicos, según un reciente informe de la Sociedad Española de Enfermedades Infecciosas y Microbiología Clínica (SEIMC). Los afectados son bastante más: 170.000.
Efectos en el turismo
El estudio británico cree que las fuerzas laborales en la UE se reducirían en un 0,6% y algo menos en Estados Unidos, un 0,4. Afectaría a todos los sectores, pero uno nos tocaría directamente a los españoles: el turístico. En el peor escenario, este capítulo sufriría pérdidas en sus ingresos anuales por valor de un 4,5%. En otros países, como Tailandia o Indonesia, estaríamos cerca del 10%.
Como hablar de porcentajes resulta abstracto, vamos a hacer un cálculo fácil. En 2024, los turistas se dejaron 126.000 millones de euros en sus vacaciones. Si aplicamos esa reducción de la que habla el informe, habría que restar casi 6.000 millones al montante total, lo que supone un buen mordisco a un sector que aporta un 15% de nuestro PIB.
Sin embargo, los investigadores británicos no se han limitado a hacer cálculos apocalípticos. Su trabajo va más allá y establece soluciones. Concretamente una: continuar con las políticas de ayuda a la investigación y el desarrollo. La lucha contra las bacterias superresistentes necesita dinero para emplearlo en tres acciones fundamentales: mejorar el acceso a tratamientos de calidad a todos enfermos, financiar programas para desarrollar nuevos antibióticos y mejorar el saneamiento y la vacunación de la población mundial.
Los programas de ayuda al exterior
Con dedicar 63.000 millones de euros cada año de aquí a 2050, se lograrían aumentar el PIB mundial en 990.000 millones de euros. En Europa el crecimiento sería de 187.000 por los 156.200 de Estados Unidos. Pero es que, además, eso incluiría ahorrar 97.000 millones de coste sanitario y evitar aproximadamente 110 millones de muertes.
El problema es que en la actualidad, las inversiones de ayuda al desarrollo en el exterior están sufriendo recortes en todos los países. Trump ha metido la tijera por un valor de 9.000 millones de dólares, Alemania ha reducido en un tercio el presupuesto para esto, y aquí, en España, le dedicamos en 2024 un 0,24% del PIB, muy lejos del 0,7% que el Gobierno se ha comprometido a alcanzar en 2030
La OMS establece las prioridades en la lucha contra estas bacterias
Las superbacterias no hay que tomárselas a broma. La OMS lleva años poniendo el foco sobre ellas y sobre la necesidad de seguir investigando para neutralizarlas. Hace un año publicó una nueva lista de las más peligrosas, que actualizaba la de 2017. Son un total de 15 familias y entre ellas se incluyen cinco bacterias causantes de infecciones respiratorias. En su criterio, este documento, que distingue entre las de prioridad crítica alta y media, debería servir para orientar los esfuerzos hacia su erradicación o hacia la obtención de fármacos capaces de ello.
«Los cambios introducidos con respecto a 2017 reflejan la dinámica de la resistencia a los antimicrobianos, que obliga a adaptar las intervenciones», señalan sus portavoces. Este organismo también destaca los graves efectos no solo en la salud, sino económicos de la resistencia antimicrobiana. Y alerta de que cada año su amenaza es mayor: «Ha aumentado desde la publicación de la primera lista, lo que mina la eficacia de numerosos antibióticos y puede echar por tierra muchos logros de la medicina moderna».
Las 5 superbacterias que provocan infecciones respiratorias que la OMS destaca
-
1
Mycobacterium tuberculosis: resistente a la rifampicina, causante de la mayor parte de los casos de tuberculosis en el mundo.
-
2
Pseudomonas aeruginosa: resistente a los carbapenémicos, que puede causar infecciones pulmonares graves.
-
3
Staphylococcus aureus: resistente a la meticilina, que también está detrás de algunas infecciones pulmonares, además de poder afectar a otros órganos.
-
4
Streptococcus pneumoniae: resistente a los macrólidos, la bacteria que con más frecuencia causa neumonía.
-
5
Haemophilus influenzae: resistente a la ampicilina, que puede originar neumonía y bronquitis
El resto de bacterias prioritarias de la OMS
-
Acinetobacter baumannii resistente a los carbapenémicos
-
Enterobacteriales resistentes a las cefalosporinas de tercera generación
-
Enterobacteriales resistentes a los carbapenémicos
-
Salmonella Typhi resistente a las fluoroquinolonas
-
Shigella spp. resistente a las fluoroquinolonas
-
Enterococcus faecium resistente a la vancomicina
-
Salmonelas no tifoideas resistentes a las fluoroquinolonas
-
Neisseria gonorrhoeae resistente a las cefalosporinas de tercera generación y/o a las fluoroquinolonas
-
Estreptococos del grupo A resistentes a los macrólidos
-
Estreptococos del grupo B resistentes a los macrólidos
¿Tienes una suscripción? Inicia sesión